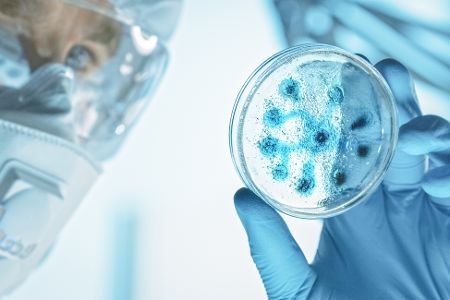
Bakterien in Petrischale

Forscher haben einen bestimmten Bakterienstamm mit Harnstoff kombiniert, um Knochen und Korallenstrukturen mithilfe eines 3D-Druckers herzustellen. Dieses Verfahren ermöglicht die Produktion von robusten und porösen Objekten, die natürlichen Vorbildern ähneln.